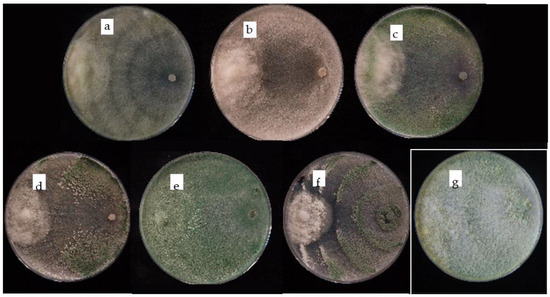

Abstract
Ink disease is a devastating disease of chestnut (Castanea sativa) worldwide, caused by Phytophthora species. The only management measures of this disease are chemical and agronomic interventions. This work focuses on the evaluation of the in vitro antagonistic capacity of 20 isolates of Trichoderma spp. selected in a diseased chestnut orchard in Tuscan Apennines (San Godenzo, Italy) for the biocontrol of Phytophthora xcambivora. Each Trichoderma isolate was tested to investigate pathogen inhibition capability by antagonism in dual cultures and antibiosis by secondary metabolites production (diffusible and Volatile Organic Compounds). The six most performing isolates of Trichoderma spp. were further assessed for their aptitude to synthesize chitinase, glucanase and cellulase, and to act as mycoparasite. All six selected isolates displayed the capability to control the pathogen in vitro by synergistically coupling antibiosis and mycoparasitism at different levels regardless of the species they belong to, but rather, in relation to specific features of the single genotypes. In particular, T. hamatum SG18 and T. koningiopsis SG6 displayed the most promising results in pathogen inhibition, thus further investigations are needed to confirm their in vivo efficacy.
1. Introduction
Castanea sativa Mill. is considered a multipurpose tree in Europe, representing an important resource exploited for fruit and timber production as well as for the characterization of mountain landscapes, in addition to its important roles in ecological and biological forest functions [1,2]. Ink disease is one of the most destructive diseases affecting chestnut, which causes root and collar rot of adult trees and of seedlings in nurseries, plantations and forest stands [3,4].
The Oomycetes Phytophthora xcambivora, and the more aggressive P. cinnamomi, are considered the causal agents of ink disease of C. sativa in Europe and the US [2]; although, in very few cases, P. citricola and P. cactorum are also reported to be associated with the disease in Northern Italy [2]. However, while P. cinnamomi is the causal agent of the disease in many European countries, causing severe losses especially in Spain, in Italy P. xcambivora is actually considered the main cause [5].
Due to the high economic and environmental value of chestnut in Italy, the most recent outbreak of ink disease has caused considerable concerns in the country [4]. After several decades of regression, the disease re-emerged probably due to climatic changes that occurred in the last 10–15 years, characterized by repeated periods of drought. Summer droughts have weakened root systems, making fine roots more susceptible to infections during the following rainy months, particularly favorable for the pathogen [1]. The symptoms of the disease appear as the necrosis of large and feeder roots that can reach the collar and the base of the trunk. This necrosis causes typical cortical-flame-shaped lesions with characteristic black exudate, which gave the name to the disease. The improper functioning of the roots leads to above ground symptoms, such as chlorosis, microphylly and wilting, which can be followed by the quick death or progressive decline of the tree, depending on the environmental conditions [2,3].
The management of ink disease is difficult. The main techniques for its containment consist of the removal of infected or dead plants from the field (eradication) or in chemical interventions that could have a negative impact both on soil and inhabiting microbial communities. The distribution of organic soil conditioners (manure, organic fertilizer) around infected plants seems to invigorate the radical system by improving soil structure and stimulating the microbial community to antagonize the pathogens [1]. Chemical fungicide hand-outs, such as potassium and aluminum salts, are only recommended in nursery, as opposed to in forest and orchards. However, these products could have a severe impact on the environment, in addition to their uncertain outcome [1].
The new EU Forest Strategy for 2030, one of the flagship initiatives of the European Green Deal, sets a vision and concrete actions to improve the quantity and quality of EU forests and strengthen their protection, restoration and resilience. In addition, European Directive 2009/128/EC and Regulation CE/1107/2009 established new rules “to achieve a sustainable use of pesticides” and the marketing of plant protection products. This can also promote integrated pest management by the use of biological control agents (BCAs) as an alternative to traditional chemicals [6].
Besides climatic and agronomic aspects, fitness and productivity of chestnuts can be influenced by the interactions established with several microorganisms, among which fungi represent the main group associated with chestnut plants, mostly in soil, that can positively or negatively affect their fitness [7]. Fungi belonging to the Trichoderma genus are widely used as beneficial fungi and are among those more frequently isolated from soil and plant root ecosystems [8]. They are marketed as active ingredients of bio-pesticides, biofertilizers, growth enhancers and stimulants of natural resistance [6]. Trichoderma spp. exert their beneficial effects by competing with the target pathogen through both exploitation and/or interference strategies. These last consist of: (i) a rapid competition for nutritive resources and (ii) growth inhibition of pathogens by releasing extracellular molecules, such as diffusible and volatile secondary metabolites [9,10,11,12], in addition to the production of cell wall degrading enzymes (CWDEs)—such as 1,3-β-glucanase and chitinase—allowing the use of pathogens cell-wall components as a nutrient to promote their growth [13,14].
Many studies report the ability of Trichoderma to act against a broad spectrum of fungal pathogens [15,16,17,18,19,20,21] and, up to now, isolates belonging to four species of Trichoderma are those more widely studied and commercialized as BCAs: T. asperellum, T. atroviride, T. harzianum and T. polysporum [8,22]. Among a plethora of studies concerning the use of Trichoderma in the management of important plant pathogens, few focus on the biological control of Phytophthora spp. [23,24,25,26], such as those related to the control of P. ycoparasii in avocado [27,28]. As far as we know, no information is available about their use to manage P. xcambivora on C. sativa, both at forest and orchard levels. Despite many studies aimed at the elaboration of biocontrol strategies in crops, the same topic is very rarely referred to the forest ecosystem.
In this study, within the framework of the LIFE MycoRestore project (LIFE 18/CCA/ES/001110) focusing on the exploitation of innovative mycological resources to improve the productivity and resilience of Mediterranean forests threatened by climate changes, the potential beneficial fitness of a pool of locally isolated Trichoderma strains has been evaluated against P. xcambivora. Especially, the biocontrol activity of Trichoderma spp. isolates has been evaluated in vitro via inhibition tests and scanning electron microscopy observations. The chitinase, glucanase and cellulase production of selected Trichoderma isolates was also evaluated.
2. Materials and Methods
2.1. Description of the Site and Soil Sampling
Samplings were performed in a mature chestnut orchard for fruit production located in the Tuscan Apennines, Castagno d’Andrea (780 m a.s.l., orientation ENE), municipality of San Godenzo (Florence, Italy), which has been partially affected by ink disease for decades [29]. The soil of the area is classified as typical hapludalfs, fine silty, mixed, mesic (Soil Taxonomy, 2003) and cutanic luvisols (Classification WRB, 1998) based on the pedological map of Tuscany Region, whereas the texture corresponded to loam [29]. Soil samples were collected around 12 asymptomatic plants located close to the core of plants affected by ink disease. Five holes 1–3 m away from the trunk and 15–20 cm deep were made, in two opposite directions, under the canopies of each asymptomatic tree. After removing the superficial litter layer, about 200 g of soil and fine roots were collected from each hole. Soil samples collected under each tree were then pooled together to obtain a single sample per tree.
2.2. Isolation of Trichoderma spp. and P. xcambivora Associated with Chestnut
Sampled roots were separated from soil and rinsed with sterile water to isolate Trichoderma from the rhizosphere. Washing water, containing rhizospheric soil, was collected and diluted up to 10−3. Each diluted sample was plated in duplicate onto Potato Dextrose Agar (PDA, 39.0 g L−1, Difco BD), amended with streptomycin sulphate (0.3 g L−1) and hymexazole (0.2 g L−1); the latter to reduce Mucoraceae development [30]. Therefore, fine roots of less than 1 mm diameter were submerged into a solution of NaClO (1.0% active chloride) in 50.0% ethanol for 1 min, then washed three times in sterile distilled water, and dried on sterile filter paper. Roots were cut into little pieces (about 7 mm length), plated onto PDA + streptomycin sulphate (0.3 g L−1) and then incubated at 25 °C for 5 days in the darkness. The colonies, whose morphology was attributable to that of Trichoderma (white or green mycelium, shape of phialides, organization of conidiogenic cells), were transferred on PDA plates. Single spore cultures were prepared for each putative Trichoderma isolate and the resulting colonies were kept on PDA tubes under mineral oil at 4 °C.
Phytophtora xcambivora was isolated from soil samples collected around symptomatic plants as described in the soil sampling section, according to Erwin and Ribeiro, 1996 [31]. In detail, 200 g of soil containing chestnut fine roots were placed into transparent plastic boxes. The roots were then accurately crumbled up and 100 mL of distilled water was added to each sample inside the box. After one hour, an additional 400 mL of distilled water was added in each box that was left overnight at room temperature. The ratio sample/water was 1:3 (v/v).
Impurities were gently removed from the water surface 24 h later, until soil was well settled on the bottom of the box and the water clear. Young leaves of rhododendron, rose, oak, ivy and chestnut were placed with the upside facing upwards on the water surface. Boxes were kept in the laboratory for 5–6 days at 20 °C. Leaf portions showing the typical Phytophthora lesions (dark spot/necrosis) were dried on sterile filter paper and plated onto Phytophthora selective medium NARPH [32]. Plates were incubated at 20 °C in darkness for 5–7 days. Phytophthora-like colonies were then transferred and maintained on PDA plates at 20 °C in darkness. All isolates are maintained at the IPSP-CNR collection of fungal germplasm.
2.3. Trichoderma and Phytophthora Isolates
Each putative Trichoderma isolate was transferred onto a 9 mm diameter sterile cellophane disc in plates containing PDA and incubated in the darkness at 25 °C for 5 days. The mycelium was collected from the membrane and lyophilized. DNA was extracted from 20 mg of lyophilized mycelium by using the NucleoSpin® Plant II kit (Macherey Nagel GmbH & Co., Düren, Germany, KG), according to the manufacturer’s instruction. Molecular identification was carried out by sequence analysis of TEF-1α (Translation elongation factor 1α). PCR amplification was performed using specific primers EF1-728_fw/TEF1LLE_rev [33,34] under the following conditions: initial denaturation at 95 °C for 1 min, 35 cycles of 94 °C for 30 s, 55 °C for 30 s, 72 °C for 90 s, and a final elongation step at 72 °C for 7 min. Genomic DNA of Phytophthora isolates was extracted as described above and molecular identification was performed by sequence analysis of the rDNA-ITS region with the ITS6/ITS4 primer pair [35]. Thermocycler parameters were 95 °C for 3 min, followed by 35 cycles of 94 °C for 1 min, 55 °C for 1 min, 72 °C for 1 min, and a final elongation at 72 °C for 10 min.
Amplicons were purified with NucleoSpin® Gel and PCR Clean-up kit (Macherey Nagel GmbH & Co., KG), quantified by using Qubit® DNA BR (Broad Range) Assay Kits (Thermo Scientific™, Waltham, MA, USA) by Invitrogen Qubit® 4 Fluorometer (Thermo Scientific™, Waltham, MA, USA) and submitted for Sanger sequencing (eurofins Genomics).
TEF1-α PCR sequences were used to identify Trichoderma spp. isolates by using the TrichOKEY v.2.0 database available on the website of the International Subcommittee of Trichoderma and Hypocrea (ISTH, www.isth.info, [36] or via GenBank (http://www.ncbi.nlm.nih.gov, accessed on 30 April 2022). The obtained sequences were also used for phylogenetic analyses with 13 reference TEF-1α sequences of Trichoderma species available in GenBank (NCBI), and one Fusarium bostrycoides selected as outgroup. GenBank accession numbers of the sequences generated in this study are shown in Table 1. The multiple sequence analysis and the construction of the neighbor-joining (NJ) phylogenetic tree were performed using MEGA 11 [37], following the Kimura-two-parameters (K2P) method [38]; 1000 bootstrap replicates were taken in order to examine the reliability of the interior branches and the validity of the trees obtained. The ambiguous nucleotide positions were removed for each sequence pair (pairwise deletion option). ITS sequences of one P. xcambivora isolate were blasted in the NCBI database to identify the most similar available sequences.
2.4. Temperature Growth Rate and Antagonistic Characterization of Trichoderma Isolates
All isolates were grown in triplicate on PDA and the mycelial radial growth was evaluated at 15 °C, 20 °C, 25 °C and 30 °C in the dark for 5 days. Daily, measurements of two perpendicular diameters of the colony were carried out to evaluate their growth rate and to explore the optimum (less stringent) experimental condition for subsequent assays. Additionally, the growth of all isolates was tested at 37 °C to verify their potential ability to live at mammalian temperature (to prevent possible interaction of those fungi with animal life). In order to find the best condition to perform all the further tests, P. xcambivora isolate was submitted to the same growth assays as described for Trichoderma spp.
Inhibition Test
For the evaluation of their biocontrol potential, Trichoderma spp. isolates were screened for their ability to reduce the mycelium growth of the locally selected P. xcambivora (strain PC003) by three different inhibition tests: (i) dual culture assay of the pathogen and each of the Trichoderma spp. isolates onto PDA dishes [39]; (ii) culture filtrate assay of Trichoderma isolates (diffusible secondary metabolites) [40]; and (iii) Sandwich Petri test volatile compounds from Trichoderma isolates on the growth of P. xcambivora [41].
For the dual culture assay, a 6 mm plug of P. xcambivora PC003 was cut from the edge of the actively growing colony on PDA, transferred at 1.5 cm from the edge of a 120 mm plate containing 20 mL of PDA and incubated at 25 °C in the dark. After 4 days, a 6 mm plug of each isolate of Trichoderma spp. was placed at the opposite side of the plates previously inoculated with the pathogen (9 cm apart), and incubated under the same conditions. Radial growth of both the pathogen and Trichoderma spp. was measured each day, four times per day, until contact [10]. Plates containing two plugs of P. xcambivora at opposite sides were prepared as negative controls, while other plates co-cultured with P. xcambivora and Radixsoil® (Isagro commercial product based on Trichoderma asperellum ICC012 and Trichoderma gamsii ICC080) were used as a positive control. For each combination, three independent replicates were performed.
The potential antibiotic activity of secondary metabolites produced by the selected Trichoderma spp. isolates against P. xcambivora PC003 was investigated. Briefly, a 6 mm PDA plug taken from actively growing colonies of each isolate of Trichoderma was inoculated in 100 mL Erlenmeyer flasks containing 20 mL of PDB (Potato Dextrose Broth, 24 g L−1) and incubated at 25 °C at 100 rpm in a rotary shaker for two weeks. Inoculated and non-inoculated PDB with Radixsoil®, incubated under the same conditions, were used as positive and negative control, respectively. Cultural filtrates of each isolate were obtained through a micropore disposable membrane (0.22 μm pore size) to remove fungal spores. Two mL of each cultural filtrate were mixed with 18 mL of PDA right before solidification (50 °C) to obtain a final concentration of 10% (v/v) and poured in Petri dishes, further inoculated at the center with 6 mm agar plug of actively growing P. xcambivora isolate on PDA and incubated at 25 °C. PDA plates containing uninoculated PDB or PDB added with Radixsoil® were used as negative and positive control, respectively. Radial growth rate (two perpendicular diameters) of P. xcambivora isolate was daily recorded in all plates for nine days until the colony reached the edge of the control plates. The test was independently repeated three times.
The production of antibiotic VOCs by each isolate of Trichoderma spp. was evaluated through the ‘Sandwich test’, according to Li et al., 2018 [41]. PDA plates were inoculated in the center with a 6 mm diameter PDA disc made from actively growing colonies of each isolate of Trichoderma spp. on PDA and incubated at 25 °C in darkness. After 4 days, the lid of the plates was removed and replaced with a new PDA plate, inoculated upside down in the center, with a 6 mm agar plug of the isolate of P. xcambivora. The two plate bases were then fixed with a double layer of parafilm and incubated at 25 °C for 5 days. Negative controls were prepared using the same experimental setup, except that an uninoculated PDA disc or PDA inoculated with a PDA agar plug of P. xcambivora isolate were used in place of that inoculated with the Trichoderma isolate, while positive control was made by inoculating PDA with Radixsoil®. The experiment was independently repeated three times. Mycelial growth (two perpendicular diameters) of P. xcambivora isolate was recorded after 5 days of incubation in all the plates.
On the basis of the results obtained from these tests, Trichoderma isolates, representative of each species, which showed the highest antagonistic ability were used for the following analysis.
2.5. Enzymatic Activity Assays
The evaluation of the enzymatic activity of Trichoderma spp. was conducted to verify the ability of each isolate to produce enzymes that could play a positive role in the interaction with the pathogen. Chitinases and glucanases activities were determined according to Harman et al., 1993 [42] and Lorito et al., 2004 [43], respectively. Since the cell wall of P. xcambivora (like all the Oomicetes) is made of cellulose and glucane, a cellulases assay was also performed.
Selected Trichoderma isolates and positive control (Radixsoil®) were inoculated in 100 mL Erlenmeyer flasks containing 20 mL of either Richard’s modified (RM) medium [42] added to 1.0% chitin (chitin suitable for analysis of chitinases, purified powder, Sigma Aldrich, St. Louis, MO, USA), or SMCS (a synthetic medium containing 680 mg KH2PO4, 870 mg K2HPO4, 200 mg KCl, 1 g NH4NO3, 200 mg CaCl2, 200 mg MgSO4·7H2O, 2 mg FeSO4, 2 mg ZnSO4, 2 mg MnSO4, 1.0% Carbossimethylcellulose (CMC, Sigma) and 5 g sucrose in 1 L of distilled water (pH 6.0) [43], respectively. Media were inoculated with an aqueous spore suspension at the final concentration of 5 × 106 conidia mL−1 and incubated for 4 days in the dark at 25 °C, on a rotary shaker at 100 rpm. Mycelium was then collected from the culture by centrifugation at 5.9 rcf for 15 min, the residual particulates were removed by filtration through a 0.22 µm filter (MF-Millipore MCE Membrane) and the cultural filtrates used for the enzymatic assay.
The chitinase activity of 1,4-β-glucosaminidase (EC 3.2.1.30) and chitobiosidase (EC 3.2.1.29) was spectrophotometrically evaluated by determining the acetylglucosaminidase (NAGasi) and chitobiosidase (Biase) activities, measuring the absorbance of p-nitrophenol released by p-nitrophenyl-β-D-N-acetylglucosaminide (Sigma) and p-nitrophenyl-β-D-N, N′-diacetylchitobiose (Sigma), respectively. Both enzymatic substrates were prepared in a potassium phosphate buffer (50 mM, pH 6.7) at a concentration of 0.3 mg mL−1. Thirty µL of enzymatic substrate and 60 µL of RM cultural filtrate of each isolate and of Radixsoil® were added in the wells of an ELISA plate and incubated at 50 °C for 30 min. RM cultural filtrate without inoculum was used as negative control.
The glucanase activity of exo-1,3-β-glucanase (EC 3.2.1.58) was evaluated by measuring the absorbance of p-nitrophenol released from p-nitrophenyl-β-D-glucopyranoside (Sigma). The substrate was prepared in potassium phosphate buffer (50 mM, pH 6.7) at a concentration of 0.3 mg mL−1. Thirty µL of enzymatic substrate and 60 µL of SMCS cultural filtrate of each isolate, and of Radixsoil®, were added in each well of an ELISA plate and incubated at 37 °C for 30 min. SMCS cultural filtrate without inoculum was used as negative control.
The reactions of these three enzymes were stopped by adding 30 µL of Na2CO3 0.4 M and the absorbance at 405 nm was measured [42]. Each test was made in triplicate. Enzymatic activity was expressed in nktal (enzyme quantity required to convert one mole of substrate in one second).
The cellulase activity assay was performed with different techniques, using the Congo Red assay [44] and the k-CellG5-2V kit (MEGAZYME, Wicklow, Ireland), following the manufacturer’s instructions. The Congo Red assay consists of a qualitative determination of cellulase activity based on the interaction of iodine with cellulose and its components in its degraded form; whereas areas with cellulose hydrolyzed by enzymes results in clear zones or the appearance of a pale halo. The halo was measured for the subsequent calculation of the enzymatic index (EI), a semi-quantitative estimate of the enzyme activities:
EI = Diameter of hydrolysis zone (halo)/Diameter of colony
Fungal samples were cultured onto water agar added with 1% CMC and incubated at 25 °C in the darkness for 10 days. The agar medium was flooded with an aqueous solution of Congo Red (1 mg mL−1, Sigma) for 15 min. The Congo Red solution was then poured off, and plates further washed by flooding with 1 M NaCl for 15 min. Immediately after, the possible presence of the halo was evident.
The Megazyme test was carried out using cultural filtrates of each sample grown in SMCS. Cultural filtrate of Radixsoil® and uninoculated liquid medium were used as positive and negative control, respectively. The kit provides a Trichoderma cellulase standard solution (3 U mL−1) to verify that the assay was correct. One unit of activity (CellG5 Unit) is defined as the amount of enzyme, in presence of thermostable β-glucosidase, required to release one μmole of 4-nitrophenol from CellG5 reagent solution (600 U mL−1 of thermostable β-glucosidase in 10% DMSO plus sodium azide) in one minute under the defined assay conditions. The calculation of CellG5 Unit was realized using the Mega-Calc sheet available on the Megazyme website (www.megazyme.com, accessed on 22 February 2022), filling the required fields with the obtained values of absorbance and the dilution of the samples used for the enzymatic assay. Both assays were carried out in triplicate for each selected isolate of Trichoderma spp.
2.6. Evaluation of the Mycoparasitic Activity by Light and Scanning Electron Microscopy
The intimate interaction occurring between the above selected isolates of Trichoderma spp., and P. xcambivora PC003 were observed under both light microscope (LM) (Zeiss, Axioskope, Germany) and Scanning Electron Microscope (SEM) (Gaia 3, Tescan s.r.o, Brno, Czech Republic). For observation at LM a sterile cellophane disk was placed on Water Agar (18.0 g L−1) plates and inoculated with a 0.5 cm plug from a PDA culture of P. xcambivora isolate positioned at the edge of each plate and incubated at 25 °C in the darkness. After three days, a 0.5 cm agar plug of each isolate of Trichoderma spp. grown on PDA, was placed in each plate, 3 cm apart from the pathogen and incubated at 25 °C. Once the two colonies came into contact with each other, a little piece of the corresponding cellophane disk was cut with a sterile scalpel and placed on a slide for microscopy. Mycelium was stained with a drop of lacto-phenol/cotton blue, covered with a coverslip, and examined at LM at 400× and 630× magnifications. SEM observations were carried out preparing dual culture plates of the selected Trichoderma isolates and P. xcambivora PC003 as described before, but without adding the cellophane layer on the agar. An agar plug made where the two colonies came into contact with each other was cut and used for observations. Samples were fixed with 2.5% glutaraldehyde in 0.1 M phosphate buffer (pH 6.7). After incubation for at least 24 h at 4 °C, samples were washed two times in 0.1 M phosphate buffer for 10 min each and dehydrated for 20 min in a graded series of ethanol (30, 50, 70, 80, 90 and 100%). Dehydrated samples were then dried to critical point using liquid carbon dioxide. Samples were mounted with double-sided tape on aluminum stubs and coated with silver particles in a coater sputter. Coated samples were observed with scanning electron microscope using an electron beam for SEM imaging at the voltage of 10 kV, operating in high-vacuum mode and with a secondary electron (SE) detector [45,46]. Evidence of mycoparasitic activity (such as Trichoderma hyphae coiling around those of the pathogen and/or degradation of the pathogen’s cell wall) was observed and photographed.
2.7. Statistical Analysis
Data on growth rates obtained from both dual cultures and secondary metabolites were subjected to analysis of variance (ANOVA) of regression by using GraphPad Prism 10 software in order to compare the slopes of P. xcambivora in control plates with that in presence of Trichoderma spp. colonies/cultural filtrates, assuming p ≤ 0.05 as a significant value.
A one-way ANOVA test of mycelium growth rate of P. xcambivora PC003 obtained from both Sandwich Petri and enzymatic activity assay (chitinases, glucanases, cellulases) assays, was performed with STATISTICA 10 using Fisher LSD test for equal N and assuming p ≤ 0.05 as significant level.
3. Results
3.1. TEF-1α and ITS rDNA Analysis
PCR amplification of TEF-1α from all the 20 Trichoderma isolates from roots and rhizosphere of C. sativa (15 endophytes and 5 from rhizosphere respectively) produced DNA fragments between 930 and 1200 bp. Sequencing of these fragments allowed to identify five different species of Trichoderma, as indicated in Table 1. In detail, isolates SG1 and SG13 were identified as T. longipile, isolate SG4 as T. asperellum, isolates SG5 and SG6 as T. koningiopsis, isolate SG19 as T. koningii while the remaining isolates (SG2, SG3, SG7, SG8, SG9, SG10, SG11, SG12, SG14, SG16, SG17, SG18, SG20 and SG21) belong all to T. hamatum species. Phylogenetic distance among isolates and species considered in this work are shown in the neighbor-joining (NJ) phylogenetic tree (Figure 1). Isolates were grouped according to the references TEF-1α from GenBank and split in two clades: Harzianum and Trichoderma. Isolates of T. hamatum, T. koningiopsis, T. asperellum and T. konigii clustered into the Trichoderma clade, while both isolates of T. longipile were grouped within the Harzianum one (Figure 1). By baiting soil samples, one isolate of P. xcambivora has been isolated. The ITS amplification of the pathogen resulted in an 844 bp sequence, identified as Phytophthora xcambivora (Accession number ON847330) showing a percentage of similarity of 99.67% with the reference found in database.

Table 1.
TEF-1α and ITS rDNA sequences examined in this study.

Figure 1.
Neighbor-joining (NJ) phylogenetic tree of Trichoderma s isolates based on TEF-1α sequence Fusarium bostrycoides was used as outgroup.
3.2. Temperature Growth Rate and Antagonistic Characterization of Trichoderma Isolates
The growth rate at different temperatures showed no difference among the 20 Trichoderma isolates. The optimum temperature of mycelium growth on PDA of all Trichoderma isolates was 25 °C, while at 37 °C, no growth was observed.
When submitted for dual culture testing aimed to evaluate the antagonistic ability of Trichoderma spp. due to diffusible metabolites, pathogen’s growth data was used to create growth curves whose analysis of variance of regression highlighted the differences when the pathogen grew alone and in the presence of each of the 20 potential antagonistic isolates (Table 2). All growth curves (alone and in each combination with the Trichoderma isolates) were highly significant as resulting from R2 and p values (≥0.731 and ≤0.0001, respectively). With respect to the ability of Trichoderma spp. isolates to affect P. cambivora growth, only in the presence of T. hamatum SG2, SG3, SG7, SG10 and SG18, of T. longipile SG13 and of T. koningi SG19 did the pathogen reduce its growth when compared with control plates. However, in each of these cases, differences in growth rates were not significant (Pslope ≥ 0.1459). By contrast, P. xcambivora paired with T. hamatum SG12 and SG16, grew faster compared with the single culture (Pslope = 0.0003 and 0.0121, respectively). The pathogen growing in the presence of the remaining isolates resulted faster than the control, but in each case, differences were not significant.

Table 2.
Mycelium growth rate from dual cultures assay between Trichoderma isolates and P. xcambivora.
Finally, the presence of Radixsoil® also did not affect the growth of P. xcambivora (Pslope = 0.5399) (Table 2 and Figure 2). The interaction occurring in dual cultures between Trichoderma isolates and P. xcambivora are shown in Figure 2, where all the beneficial organisms evidenced the capability to overgrow the pathogen and sporulate on it.
Figure 2.
Dual cultures of Trichoderma isolates (right) against P. xcambivora PC003 (left) on PDA medium after 9 (a–d,f) and 14 (e,g) days at 25 °C. (a) T. longipile SG1); (b) T. asperellum SG4; (c) T. koningiopsis SG6; (d) T. hamatum SG18; (e) T. koningii SG19; (f) T. hamatum SG20; (g) Radixsoil®.
When the Trichoderma isolates were tested for their ability to release secondary metabolites with an inhibiting activity, the growth rate of P. xcambivora on PDA was compared with that registered on PDA, added with the cultural filtrates of each isolate of Trichoderma. Analysis of variance of regression performed on growth data allowed for the observing of a different behavior of the pathogen depending on the cultural filtrates (Table 3). Filtrate culture assay showed highly significant growth curves as resulting from R2 and p values, (≥0.789 and ≤0.0001, respectively). No mycelial development was observed in P. cambivora PC003 grown with culture filtrates of T. hamatum SG14 and SG20, as confirmed by the slope values (0.819 and 0.000 mm per day, respectively). A significantly lower growth rate was also detected with T. longipile SG1 and SG13, and T. hamatum SG8 and SG18, compared to control (Pslope ≤ 0.001). On the other hand, a relevant increase in growth rate was found in P. xcambivora PC003 grown with all other culture filtrates of Trichoderma (Pslope ≤ 0.012), except for T. hamatum SG2, SG7 and SG17, and T. koningiopsis SG5 which showed no difference (Table 3).

Table 3.
Mycelium growth rate of P. xcambivora PC003 inoculated on PDA added with the cultural filtrates of Trichoderma isolates.
In the Sandwich Petri test, P. xcambivora PC003 fungal growth, after 5 days of incubation, showed a significant inhibition in colony growth in combination with T. koningiopsis SG5 and SG6, while together with T. hamatum SG18 no growth was observed (Table 4 and Figure 3). Radixsoil® significantly reduced pathogen’s growth, too. According to all the results described above, the most performing Trichoderma isolates for each species, able to contain P. xcambivora growth, were selected: T. longipile SG1, T. asperellum SG4, T. koningiopsis SG6, T. koningii SG19 and T. hamatum SG 18 and SG20, and used for further analysis.

Table 4.
Enzymatic activity of the selected Trichoderma isolates.

Figure 3.
Effect of volatile metabolites (sandwich test) produced by Trichoderma spp. isolates on P. xcambivora PC003 growth (mm) on PDA after 5 days of incubation. At different letters correspond values significantly different for p ≤ 0.05 (One-way ANOVA, Fisher LSD test for equal N). Values are the average of three independent replicates. (Blue) T. hamatum; (green) T. koningiopsis; (dark blue) Radixsoil®; (purple) T. koningii; (yellow) T. asperellum; (orange) T. longipile; (red) P. xcambivora (Phy).
3.3. Enzymatic Activity Assays
All the selected Trichoderma isolates grown in RM liquid medium added with 1% chitin showed a chitinase activity after 4 days of incubation (Table 4). NAGase activity was higher compared to Biase enzymatic activity for all the selected Trichoderma isolates. A significant lower level of NAGase activity was detected in Trichoderma asperellum (SG4) compared to the control (0.798 nktal), while T. longipile SG1 and T. koningiopsis SG6 and Radixsoil® showed the higher enzymatic activity (1.129, 1.107 vs. 1.103 nktal, respectively). Trichoderma koningii SG19 and both the isolates of T. hamatum (SG18 and SG20) showed an intermediate NAGase activity (0.987, 0.934 and 0.915 nktal respectively). Concerning the Biase activity T. asperellum SG4 (0.193 nktal), T. hamatum SG20, T. koningii SG19 and T. hamatum SG18, showed a significantly lower activity compared to the control with values of 0.394, 0.496 and 0.546 nktal, respectively. On the other hand, T. longipile SG1 and T. koningiopsis SG6 showed a Biase activity (0.706 and 0.693 nktal, respectively) similar to that of Radixsoil® (0.698 nktal) (Table 4).
Glucanase activity was detected for all Trichoderma isolates grown in SMCS liquid medium supplemented with 1% CMC after 4 days of incubation (Table 4). In detail, the highest production of glucanase was obtained for T. koningiopsis SG6 (1.174 nktal), even significantly higher than that of Radixsoil® (0.127 nktal, p < 0.01)). T. longipile SG1 and T. asperellum SG4 revealed the lowest enzymatic activity compared to the other isolates and to the positive control, with 0.16 and 0.21 nktal versus 1.13 nktal of Radixsoil®. T. longipile SG1 and T. asperellum SG4 showed the significantly lowest glucanase activity (0.157 and 0.213 nktal, respectively) followed by T. hamatum SG18 and SG20 (0.474 and 0.808 nktal, respectively).
Cellulase activity performed by the Congo Red assay showed that, among the tested isolates, T. hamatum SG20 displayed the best capability to produce cellulase, followed by T. koningiopsis SG6 and T. koningii SG19, whose enzymatic index were significantly different from Radixsoil. Trichoderma asperellum SG4 resulted in the less efficient isolate in cellulase activity (Table 4). A further cellulase assay implemented by the Megazyme kit resulted as not efficient for all the tested isolates, despite the fact that the assay was successfully carried out since the CellG5 Unit of the standard showed a positive value (12.6 Units/mL).
3.4. Evaluation of the Mycoparasitic Activity by Light and Scanning Electron Microscopy
Observations performed with light microscope and SEM, revealed an active interaction between the isolates of Trichoderma and that of P. xcambivora PC003. All Trichoderma isolates, except T. longipile SG1 grew along P. xcambivora hyphae, often branching profusely and developing coilings in order to increase the contact with the pathogen mycelium (Figure 4B and Figure 5) [57]. Moreover, hyphae of P. xcambivora appeared extensively deformed, collapsed or broken (Figure 4 and Figure 5). At last, a profuse sporulation of the beneficial isolates is visible on the pathogen, as for T. koningii SG19 (Figure 5D).

Figure 4.
Dual culture observation of Trichoderma koningiopsis (SG6) vs. P. xcambivora at light microscope (LM; 630×): (A) hyphae of T. koningiopsis (red narrows) and of P. xcambivora (white narrows); (B) coilings of T. koningiopsis (red arrows) choking the hyphae of P. xcambivora (white arrows).

Figure 5.
Observations of Trichoderma vs. P. xcambivora in dual culture at SEM. Coilings of (A) T. hamatum SG18; (B) T. koningii SG19; (C) T. asperellum SG4 (all indicated with red narrows) around P. xcambivora hyphae (white narrow). (D) Spore production (green arrows) of T. koningii SG19 on P. xcambivora mycelium (white arrow).
The aptitude of each selected Trichoderma isolate to adopt different antagonistic strategies is summarised in Table 5.

Table 5.
Schematic representation of the biocontrol strategies adopted by the different Trichoderma isolates.
4. Discussion
Trichoderma spp. act as biocontrol agents implementing four different strategies to reduce the growth of the pathogen: competition for nutrients in the same growing space, antibiosis by producing secondary metabolites (diffusible and VOCs) toxic for the pathogen, mycoparasitism by the formation of coilings, and synthesis of the cell wall degrading enzyme [58,59,60]. One of the best strategies to isolate effective beneficial fungi to be used against a specific pathogen is to search/investigate around healthy plants within the outbreaks of a disease or in places where the development of the pathogen is promoted [61,62]. According to this evidence, in this study, 20 Trichoderma spp. isolates were collected from rhizosphere and fine roots of asymptomatic chestnut trees growing inside an area affected by ink disease caused by the Oomycetes P. xcambivora [29]. The collected isolates belong to five different species (T. asperellum, T. hamatum, T. koningii, T. koningiopsis, T. longipile), which are grouped into two clades (Trichoderma and Viride) according to the neighbor-joining tree constructed on TEF-1α gene marker [63] (Figure 1). These are cosmopolitan species already isolated from soil and as endophytes, with the exception of T. koningii and T. longipile, whose presence was found in some areas of Europe and North America [40,64,65]. These species, but T. longipile, were already isolated in soil from different forest ecosystems (hazelnut orchards, conifer and broadleaf mixed forest), although a higher biodiversity of the Trichoderma population was reported by Rees et al., 2021 [21] and Ma et al., 2020 [66] compared to that found in this study. To our knowledge, no information is currently available on the Trichoderma community associated with Castanea sativa. In the present study, all the isolates were tested in vitro for their inhibition activity against P. xcambivora, the causal agent of ink disease, thus assessing the strategy, or the strategies, by which the characterized Trichoderma can act as biocontrol agents. Then, the most performing ones were selected to be used, for the first time, in a new possible biological approach for an integrated management of ink disease.
It is well known that Trichoderma spp. exhibit a fast up-take of nutrient resources from soil, creating a non-favorable environment for the other rhizosphere microorganisms and leading to a natural management of fungal communities [59,67]. The antagonism activity of the selected Trichoderma isolates by diffusible SMs was assessed in this study, evaluating the interaction between the colonies of each Trichoderma isolate with that of P. xcambivora after 14 days of co-culturing (dual culture) on PDA medium. All putative antagonists completely overgrew and sporulated on the colony of the pathogen, particularly some isolates of T. hamatum (SG2, SG3, SG7, SG10, SG18), T. longipile SG13 and T. koningii SG19 that induced a growth slowdown of P. xcambivora in dual cultures (Table 2). These features represent a very important characteristic to be evaluated in several species of Trichoderma used as beneficial fungi against several plant pathogens, in both forest and crop patho-systems. In particular, T. harzianum, T. atroviride, T. virens, T. koningiopsis, T. hamatum and T. asperellum were reported to overgrow and sporulate on the target pathogen in dual cultures, the latter considered as a sign of mycoparasitism [21,27,68,69,70,71].
P. xcambivora growth stimulation, here observed when in presence of T. longipile SG1 and two isolates of T. hamatum (SG12 and SG16) (Table 2), could be considered as a reaction to the presence of the antagonist sharing the same plate, i.e., as a response of the pathogen to an adverse environment. This behavior has already been observed in other pathogen-Trichoderma dual cultures (F. graminearum vs. T. gamsii) where faster growth of the pathogen was explained by Zapparata et al., 2021 [11] as probably due to the lack of nutrients (which can stimulate an initial overgrowth to escape the stressful situation) or the sensing of secondary metabolites synthetized by Trichoderma, which stimulate ‘the prey’ to accelerate its growth.
Direct antagonistic activity exerted by Trichoderma also implies a cross-talk between the antagonist and the pathogen during which the sensing of secondary metabolites (SMs) diffused across the media, or released in the shared headspace, interferes with fungal cellular activities [58]. As well as for all microorganisms, Trichoderma SMs play pivotal roles in chemical defense and communication, and some of them are largely studied, showing antibiotic abilities to be of importance in biocontrol applications (peptaibols, polyketides, pyrones, terpenes and diketopiperazine-like compounds) [72]. Among these compounds, 6-penthyl-α-pyrone (6-PP) is the most studied for its antifungal property and is responsible for the “coconut aroma” associated with some species of Trichoderma, such as T. harzianum, T. virens, T. asperellum [59,73,74,75,76], and that in our study was observed in all the tested T. hamatum isolates, and weakly in T. asperellum SG4. In this study, the capability of Trichoderma to act through antibiosis strategy was assessed by also evaluating the eventual release of diffusible and volatile secondary metabolites, as well as their inhibitory activity towards the growth of P. xcambivora in vitro. Each tested Trichoderma showed a different inhibition degree of P. xcambivora growth due to SMs (both diffusible and volatile), which appeared unrelated to the species they belong to, but rather to specific features of the single genotypes. For the first time, the effectiveness of T. longipile SG1 and T. hamatum SG20 diffusible SMs in the inhibition of P. xcambivora in vitro was documented here, showing a strong (SG1) or total (SG20) inhibition of mycelium growth of the pathogen (Table 3). In recent studies, the crude extract from T. harzianum, T. viride, T. reesei, T. asperellum and T. asperelloides is reported to inhibit the development of P. palmivora lesions on palm oil [77,78,79], and a treatment with T. atroviride and T. petersenii extract inhibited Phytophthora growth, inducing defense-related genes [80].
Noteworthy results were obtained through T. koningiopsis (SG5, SG6) and T. hamatum SG18 VOCs emission, which strongly or totally prevented mycelial growth of P. xcambivora in vitro (Figure 3). Similar results were obtained by Elsherbiny et al., 2020 [81], revealing that VOCs emitted by two strains of T. atroviride induced 80% inhibition of mycelial growth of the pathogen. Given the promising results of this study, further investigations will be devoted to the characterization of the pool of both diffusible and volatile SMs in the selected Trichoderma isolates by GC-MS/SPME (VOCs) and HPLC (diffusible compounds).
In addition to SMs, a set of lytic enzymes are also produced by Trichoderma enhancing the host cell wall lysis, whose components can then be used as nutritional resources. Chitinases and β-1,3-glucanases are the best studied groups of CWDEs within the genus Trichoderma—being strictly associated with the mycoparasitic lifestyle—to the point that their number has been documented to be higher than in other filamentous fungi [82]. In particular, T. atroviride, T. virens and T. reesei are reported to produce higher chitinases and glucanases activity in comparison to other Ascomycetes [82,83]. T. reesei and T. koningii are the best-known producers of cellulolytic enzymes [84], mainly studied for the improvement of industrial cellulases production processes and more recently in biofuel applications [85]. In the present study, chitinases (NAGase and Biase) and glucanases activities of the cultural filtrates of the six selected Trichoderma isolates were determined. Moreover, cellulases activity was investigated by biochemical and colorimetric assays since cellulose is the main component of the cell wall of the fungal-like P. xcambivora [86]. Chitinases and glucanases activities appear to be isolate-specific: T. koningiopsis SG6 and T. hamatum SG20 displayed the best performances, followed by T. hamatum SG18 (Table 4). Similar results were obtained for T. asperellum, T. harzianum, T viride, T. hamatum and T. koningiopsis in response to phytopathogenic fungi in biocontrol studies [70,87,88]. The synergic action of SMs and lytic enzymes offers a more advanced level of antagonism than the performance of either antibiotics or enzymes acting alone [61]. We can likely infer that, isolates displaying the best performances in both SMs and lytic enzymes tests, develop the best aptitude to act against the pathogen by exerting an antibiosis strategy, as observed for T. koningiopsis SG6 and T. hamatum SG 18 and SG20. The lack or very low cellulases activity showed by the tested Trichoderma—including the positive control Radixsoil®—using the commercial “megazyme assay” could depend on cultivation conditions (pH) and, more presumably, on the high carbon and nitrogen sources present in the growing media. In fact, it is observed that the use of sugars as a carbon source leads to a repression of cellulases encoding genes transcription [89]. A different result was obtained testing the same enzymatic activity in water agar added with 1% CMC as carbon source. All isolates showed a different behavior in terms of cellulases biosynthesis, regardless of the species they belong to, demonstrating again that each isolate displays specific features related to its genotype. T. hamatum SG20 showed the higher cellulases activity, followed by T. koningiopsis SG6 and T. koningii SG19 (Table 4) in contrast with what demonstrated by Rabinal et al., 2020 [90], which showed a very low cellulases activity by the latter two species. In the same work, a very weak cellulases activity was reported for T. longipile, similar to results obtained in this study [90]. The synthesis of lytic enzymes generally occurs right before and during the physical contact between the antagonist and the recognized prey, followed by the formation of twists of Trichoderma around the pathogen’s hyphae, thus penetrating them by developing appressoria [7,90,91]. This is a mycoparasitic mechanism implemented by Trichoderma against a target pathogen and represents an important condition to be observed for an effective use of these beneficial fungi [92]. This strategy is very well documented in several species of the genus and is considered as one of the major mechanisms involved in the antagonistic activity. The hyperparasitism of T. harzianum against F. solani by coilings formation was already reported by Kumar et al., 1998 [93] and more recently described also for T. koningii, T. viride, T. hamatum and T. asperellum with regards to several fungal pathogens and Oomycetes [94,95,96]. Coilings formation of the tested isolates in this study was evaluated by both a light and scanning electron microscope, revealing that all the selected Trichoderma isolates showed this aptitude but T. longipile SG1, which was still able to overgrow P. xcambivora in dual cultures (Figure 4 and Figure 5). Since no literature is currently available regarding the mycoparasitic strategy implemented by T. longipile, it could be proposed that such isolate exerts its beneficial effect through the mechanism of antibiosis, mainly producing diffusible secondary metabolites with a strong inhibitory effect on the growth of P. xcambivora.
The in vitro selection process of putative BCAs is crucial to understand the features of the studied isolates before deeply exploring their efficacy in vivo. Indeed, the beneficial behavior of Trichoderma is a complex trait to be predicted, since a given strain can synchronously use several strategies or even act in different ways against different pathogens. This is the case of T. asperellum tested in this study, the results of which are less efficient in the inhibition of P. xcambivora in vitro, compared to the other examined isolates; although, it is well recognized in the literature as one of the most performing Trichoderma-based biocontrol agents in the management of several plant diseases [97,98,99].
To our knowledge, this is the first time that Trichoderma isolates belonging to hamatum, koningii, koningiopsis and longipile species have been tested for the specific management of P. xcambivora. All the selected isolates displayed the capability to control the pathogen in vitro acting by coupling synergistically antibiosis and mycoparasitism at different levels. In detail, T. hamatum SG18 and SG20, T. koningiopsis SG6 and T. koningii SG19 isolates positively replied to all the tests herein performed, T. longipile mainly used antibiosis and T. asperellum mainly acted as mycoparasite as demonstrated by the coilings differentiated around the pathogen’s mycelium. Particularly relevant results were shown by T. hamatum SG18 and T. koningiopsis SG6, raising a strong interest for their capability to highly inhibit the growth of the pathogen. They could be promising isolates for an innovative and environmentally friendly approach for ink disease management; thus, further investigations are needed to also confirm their efficacy in vivo. Given the hybrid nature of P. xcambivora, future investigations should take into consideration several strains of the pathogen, and their respecting mating types, to evaluate the efficacy of the selected beneficial organism on the representative pathogen population diversity.
Author Contributions
Conceptualization and supervision, A.F., G.D.R. and S.S.; laboratory experiment, A.F. and C.S.; data curation, A.F., G.D.R., S.S. and G.E.; writing—original draft preparation, A.F.; writing—review and editing, A.F., S.S., A.M., F.V., C.S., R.D., G.E., S.B. and G.D.R. All authors have read and agreed to the published version of the manuscript.
Funding
This research was funded by the European Union with the LIFE MycoRestore project, grant number LIFE/18/CCA/ES/001110.
Institutional Review Board Statement
Not applicable.
Informed Consent Statement
Not applicable.
Data Availability Statement
Not applicable.
Acknowledgments
The authors want to thank the coordinator of the LIFE project, Alvaro Peix, the farm ‘Le Casine di Salieri Giuseppe’ for hosting the demonstrative project area, the technicians Vincenzo Di Lonardo and Stefano Secci for helping in the field work. Thanks to Duccio Migliorini and Simone Luti for their suggestions about laboratory assays. We also appreciate, for the various support to the project and to the research, the Tuscany Region, the Foreste Casentinesi, Monte Falterona e Campigna National Park, the Unione dei Comuni Valdarno e Valdisieve, the Consorzio Promozione Tutela Marrone del Mugello IGP, the municipality of San Godenzo and the Montagne Fiorentine Model Forest.
Conflicts of Interest
The authors declare no conflict of interest. The funders had no role in the design of the study; in the collection, analyses, or interpretation of data; in the writing of the manuscript, or in the decision to publish the results.
References
- Turchetti, T.; Maresi, G. Biological Control and Management of Chestnut Diseases in Integrated Management of Diseases Caused by Fungi, Phytoplasma and Bacteria; Springer: Berlin/Heidelberg, Germany, 2008; pp. 85–118. [Google Scholar]
- Vettraino, A.M.; Morel, O.; Perlerou, C.; Robin, C.; Diamandis, E.; Vannini, A. Occurrence and distribution of Phytophthora species in European chestnut stands, and their association with Ink Disease and crown decline. Eur. J. Plant Pathol. 2005, 111, 169–180. [Google Scholar] [CrossRef]
- Vannini, A.; Vettraino, A.M. Ink disease in chestnuts: Impact on the European chestnut. For. Snow Landsc. Res. 2001, 76, 345–350. [Google Scholar]
- Vettraino, A.M.; Natili, G.; Anselmi, N.; Vannini, A. Recovery and pathogenicity of Phytophthora species associated with a resurgence of ink disease in Castanea sativa in Italy. Plant Pathol. 2001, 50, 90–96. [Google Scholar] [CrossRef] [Green Version]
- Robin, C.; Morel, O.; Vettraino, A.M.; Perlerou, C.; Diamandis, S.; Vannini, A. Genetic variation in susceptibility to Phytophthora xcambivora in European chestnut (Castanea sativa). For. Ecol. Manag. 2006, 226, 199–207. [Google Scholar] [CrossRef]
- Woo, S.L.; Ruocco, M.; Vinale, F.; Nigro, M.; Marra, R.; Lombardi, N.; Lorito, M. Trichoderma-based products and their widespread use in agriculture. Open Mycol. J. 2004, 8, 71–126. [Google Scholar] [CrossRef] [Green Version]
- Nicoletti, R.; Beccaro, G.L.; Sekara, A.; Cirillo, C.; Di Vaio, C. Endophytic Fungi and Ecological Fitness of Chestnuts. Plants 2001, 10, 542. [Google Scholar] [CrossRef]
- Harman, G.E.; Howell, C.R.; Viterbo, A.; Chet, I.; Lorito, M. Trichoderma species—Opportunistic, avirulent plant symbionts. Nat. Rev. Microbiol. 2004, 2, 43–56. [Google Scholar] [CrossRef]
- Sarrocco, S.; Vannacci, G. Preharvest application of beneficial fungi as a strategy to prevent postharvest mycotoxin contamination: A review. Crop Prot. 2018, 110, 160–170. [Google Scholar] [CrossRef]
- Sarrocco, S.; Valenti, F.; Manfredini, S.; Esteban, P.; Bernardi, R.; Puntoni, G.; Vannacci, G. Is exploitation competition involved in a multitrophic strategy for the biocontrol of fusarium head blight? Phytopathology 2019, 109, 560–570. [Google Scholar] [CrossRef] [Green Version]
- Zapparata, A.; Baroncelli, R.; Durling, M.B.; Kubicek, C.P.; Karlsson, M.; Vannacci, G.; Sarrocco, S. Fungal cross-talk: An integrated approach to study distance communication. Fungal Genet. Biol. 2021, 148, 103518. [Google Scholar] [CrossRef]
- Vicente, I.; Baroncelli, R.; Hermosa, R.; Monte, E.; Vannacci, G.; Sarrocco, S. Role and genetic basis of specialised secondary metabolites in Trichoderma ecophysiology. Fungal Biol. Rev. 2022, 39, 83–99. [Google Scholar] [CrossRef]
- Saravanakumar, K.; Yu, C.; Dou, K.; Wang, M.; Li, Y.; Chen, J. Synergistic effect of Trichoderma-derived antifungal metabolites and cell wall degrading enzymes on enhanced biocontrol of Fusarium oxysporum f. sp. cucumerinum. Biol. Control 2016, 94, 37–46. [Google Scholar] [CrossRef]
- Saravanakumar, K.; Li, Y.; Yu, C.; Wang, Q.Q.; Wang, M.; Sun, J.; Chen, J. Effect of Trichoderma harzianum on maize rhizosphere microbiome and biocontrol of Fusarium Stalk rot. Sci. Rep. 2017, 7, 1771. [Google Scholar] [CrossRef] [PubMed]
- Rojo, F.G.; Reynoso, M.M.; Ferez, M.; Chulze, S.N.; Torres, A.M. Biological control by Trichoderma species of Fusarium solani causing peanut brown root rot under field conditions. Crop Prot. 2007, 26, 549–555. [Google Scholar] [CrossRef]
- Zancan, W.L.A.; Machado, J.C.; de Sousa, B.F.M.; Matos, C. Mycelial growth, production and germination of sclerotia of Sclerotinia sclerotiorum in the presence of fungicides and Trichoderma harzianum. Biosci. J. 2012, 28, 782–789. [Google Scholar]
- Kullnig, C.; Mach, R.L.; Lorito, M.; Kubicek, C.P. Enzyme diffusion from Trichoderma atroviride (=T. harzianum P1) to Rhizoctonia solani is a prerequisite for triggering of Trichoderma ech42 gene expression before mycoparasitic contact. Appl. Environ. Microbiol. 2000, 66, 2232–2234. [Google Scholar] [CrossRef] [Green Version]
- Morán-Diez, E.; Hermosa, R.; Ambrosino, P.; Cardoza, R.E.; Gutiérrez, S.; Lorito, M.; Monte, E. The ThPG1 endopolygalacturonase is required for the Trichoderma harzianum—Plant beneficial interaction. Mol. Plant. Microbe Interact. 2009, 22, 1021–1031. [Google Scholar] [CrossRef] [Green Version]
- Wharton, P.S.; Kirk, W.W.; Schafer, R.L.; Tumbalam, P. Evaluation of biological seed treatments in combination with management practices for the control of seed-borne late blight in potato. Biol. Control 2012, 63, 326–332. [Google Scholar] [CrossRef]
- Becker, E.M.; Rajakulendran, N.; Shamoun, S.F. Trichoderma spp. Antagonistic effects to Phytophthora ramorum growth and spore germination in vitro. In Proceedings of the Plant Canada Conference, Halifix, NS, Canada, 17–21 July 2011; pp. 173–174. [Google Scholar]
- Rees, H.J.; Bashir, N.; Drakulic, J.; Cromey, M.G.; Bailey, A.M.; Foster, G.D. Identification of native endophytic Trichoderma spp. for investigation of in vitro antagonism towards Armillaria mellea using synthetic-and plant-based substrates. J. Appl. Microbiol. 2021, 131, 392–403. [Google Scholar] [CrossRef]
- Chao, W.; Zhuang, W. Evaluating effective Trichoderma isolates for biocontrol of Rhizoctonia solani causing root rot of Vigna unguiculata. J. Integr. Agric. 2019, 18, 2072–2079. [Google Scholar]
- Segarra, G.; Aviles, M.; Casanova, E.; Borrero, C.; Trillas, I. Effectiveness of biological control of Phytophthora capsici in pepper by Trichoderma asperellum strain T34. Phytopathol. Mediterr. 2013, 52, 77–83. [Google Scholar]
- Mbarga, J.B.; Begoude, B.A.D.; Ambang, Z.; Meboma, M.; Kuaté, J.; Schiffers, B.; Ewbank, W.; Dedieu, L.; Ten Hoopen, G.M. A new oil-based formulation of Trichoderma asperellum for the biological control of cacao black pod disease caused by Phytophthora megakarya. Biol. Control 2014, 77, 15–22. [Google Scholar] [CrossRef] [Green Version]
- Sánchez, A.D.; Ousset, M.J.; Sosa, M.C. Biological control of Phytophthora collar rot of pear using regional Trichoderma strains with multiple mechanisms. Biol. Control 2019, 135, 124–134. [Google Scholar] [CrossRef]
- Hanada, R.E.; Pomella, A.W.; Soberanis, W.; Loguercio, L.L.; Pereira, J.O. Biocontrol potential of Trichoderma martiale against the black-pod disease (Phytophthora palmivora) of cacao. Biol. Control 2009, 50, 143–149. [Google Scholar] [CrossRef]
- Andrade-Hoyos, P.; Silva-Rojas, H.V.; Romero-Arenas, O. Endophytic Trichoderma species isolated from Persea americana and Cinnamomum verum roots reduce symptoms caused by Phytophthora cinnamomi in avocado. Plants 2020, 9, 1220. [Google Scholar] [CrossRef]
- Macías-Rodríguez, L.; Guzmán-Gómez, A.; García-Juárez, P.; Contreras-Cornejo, H.A. Trichoderma atroviride promotes tomato development and alters the root exudation of carbohydrates, which stimulates fungal growth and the biocontrol of the phytopathogen Phytophthora cinnamomi in a tripartite interaction system. FEMS Microbiol. Ecol. 2018, 94, 137. [Google Scholar] [CrossRef] [Green Version]
- Venice, F.; Vizzini, A.; Frascella, A.; Emiliani, G.; Danti, R.; Della Rocca, G.; Mello, A. Localized reshaping of the fungal community in response to a forest fungal pathogen reveals resilience of Mediterranean mycobiota. Sci. Total Environ. 2021, 800, 149582. [Google Scholar] [CrossRef]
- Fiorini, L.; Guglielminetti, L.; Mariotti, L.; Curadi, M.; Picciarelli, P.; Scartazza, A.; Sarrocco, S.; Vannacci, G. Trichoderma harzianum T6776 modulates a complex metabolic network to stimulate tomato cv. Micro-Tom growth. Plant Soil 2016, 400, 351–366. [Google Scholar] [CrossRef]
- Erwin, D.C.; Ribeiro, O.K. Phytophthora: Diseases Worldwide; n. 632.4 E73p; APS Press: St. Paul, MS, USA, 1996. [Google Scholar]
- Hüberli, D.; Hardy, G.S.J.; White, D.; Williams, N.; Burgess, T.I. Fishing for Phytophthora from Western Australia’s waterways: A distribution and diversity survey. Australas. Plant Pathol. 2013, 42, 251–260. [Google Scholar] [CrossRef]
- Carbone, I.; Kohn, L.M. A method for designing primer sets for speciation studies in filamentous ascomycetes. Mycologia 1999, 91, 553–556. [Google Scholar] [CrossRef]
- Jaklitsch, W.M.; Komon, M.; Kubicek, C.P.; Druzhinina, I.S. Hypocrea voglmayrii sp. nov. from the Austrian Alps represents a new phylogenetic clade in Hypocrea/Trichoderma. Mycologia 2005, 97, 1365–1378. [Google Scholar] [CrossRef] [PubMed]
- White, T.J.; Bruns, T.; Lee, S.; Taylor, J. Amplification and direct sequencing of fungal ribosomal RNA genes for phylogenetics. PCR Protoc. Guide Methods Appl. 1990, 18, 315–322. [Google Scholar]
- Druzhinina, I.S.; Kopchinskiy, A.G. TrichOKEY v. 2-A DNA Oligonucleotide BarCode Program for the Identification of Multiple Sequences of Hypocrea and Trichoderma. In Proceedings of the 8th International Mycological Congress; Meyer, W., Pearce, C., Eds.; Medimond: Bologna, Italy; Cairns, Australia, 2006. [Google Scholar]
- Tamura, K.; Stecher, G.; Kumar, S. MEGA11: Molecular evolutionary genetics analysis version 11. Mol. Biol. Evol. 2021, 38, 3022–3027. [Google Scholar] [CrossRef] [PubMed]
- Kimura, M. A simple method for estimating evolutionary rates of base substitutions through comparative studies of nucleotide sequences. J. Mol. Evol. 1980, 16, 111–120. [Google Scholar] [CrossRef] [PubMed]
- Lahlali, R.; Serrhini, M.N.; Friel, D.; Jijakli, M.H. Predictive modelling of temperature and water activity (solutes) on the in vitro radial growth of Botrytis cinerea Pers. Int. J. Food Microbiol. 2007, 114, 1–9. [Google Scholar] [CrossRef]
- Campanile, G.; Ruscelli, A.; Luisi, N. Antagonistic activity of endophytic fungi towards Diplodia corticola assessed by in vitro and in planta tests. Eur. J. Plant Pathol. 2007, 117, 237–246. [Google Scholar] [CrossRef]
- Li, N.; Alfiky, A.; Wang, W.; Islam, M.; Nourollahi, K.; Liu, X.; Kang, S. Volatile compound-mediated recognition and inhibition between Trichoderma biocontrol agents and Fusarium oxysporum. Front. Microbiol. 2018, 9, 2614. [Google Scholar] [CrossRef]
- Harman, G.E.; Hayes, C.K.; Lorito, M.; Broadway, R.M.; Di Pietro, A.; Peterbauer, C.; Tronsmo, A. Chitinolytic enzymes of Trichoderma harzianum: Purification of chitobiosidase and endochitinase. Phytopathology 1993, 83, 313–318. [Google Scholar] [CrossRef]
- Lorito, M.; Hayes, C.K.; Di Pietro, A.; Woo, S.L.; Harman, G.E. Purification, characterization, and synergistic activity of a glucan 1, 3-beta-glucosidase and an N-acetyl-beta-glucosaminidase from Trichoderma harzianum. Phytopathology 1994, 84, 398–405. [Google Scholar] [CrossRef]
- Coronado-Ruiz, C.; Avendaño, R.; Escudero-Leyva, E.; Conejo-Barboza, G.; Chaverri, P.; Chavarría, M. Two new cellulolytic fungal species isolated from a 19th-century art collection. Sci. Rep. 2018, 8, 7492. [Google Scholar] [CrossRef] [Green Version]
- Pembroke, E.; Ruan, G.; Sinitskii, A.; Corley, D.A.; Yan, Z.; Sun, Z.; Tour, J.M. Effect of anchor and functional groups in functionalized graphene devices. Nano Res. 2013, 6, 138–148. [Google Scholar] [CrossRef]
- Manzali, D.; Nipoti, P.; Pisi, A.; Filippini, G.; D’Ercole, N. Scanning electron microscopy study of in vitro antagonism of Trichoderma spp. strains against Rhizoctonia solani Kühn. Phytopathol. Mediterr. 1993, 32, 1–6. [Google Scholar]
- Jaklitsch, W.M.; Voglmayr, H. Biodiversity of Trichoderma (Hypocreaceae) in Southern Europe and Macaronesia. Stud. Mycol. 2015, 80, 1–87. [Google Scholar] [CrossRef] [PubMed] [Green Version]
- Syd Abdul Rahman, S.S.M.; Mohd Zainudin, N.A.I. Characterization of Trichoderma Species Isolated from Soil and Efficacy of Trichoderma asperellum as Biocontrol Agent of Fusarium wilt Disease of Banana. Ph.D. Thesis, Universiti Putra Malaysia, Seri Kembangan, Malaysia, 2017, unpublished. [Google Scholar]
- Chen, K. Identification and function evaluation of Trichoderma gamsii TW20050. 2016; unpublished. [Google Scholar]
- Skoneczny, D.; Oskiera, M.; Szczech, M.; Bartoszewski, G. Genetic diversity of Trichoderma atroviride strains collected in Poland and identification of loci useful in detection of within-species diversity. Folia Microbiol. 2015, 60, 297–307. [Google Scholar] [CrossRef] [PubMed] [Green Version]
- Cambon, M.; Lapeyre, L.; Raptopoulo, A.; Industri, B.; Canaguier, R.; Punchet, M. Finnover Interreg project: Characterization of endophytic fungal communities from southern French Mediterranean halophilic plants. 2020; unpublished. [Google Scholar]
- Nakari, T.; Alatalo, E.; Penttilä, M.E. Isolation of Trichoderma reesei genes highly expressed on glucose-containing media: Characterization of the tef1 gene encoding translation elongation factor 1α. Gene 1993, 136, 313–318. [Google Scholar] [CrossRef]
- Hatvani, L.; Mlinaric-Missoni, E.; Manikandan, P.; Doczi, I.; Atanasova, L.; Ivanyi, B.; Bogats, G.; Naredran, V.; Revathi, R.; Kariyankode, K.C.; et al. Agricultural Systems as Potential Sources of Emerging Human Mycoses Caused by Trichoderma: T. bissettii Joins T. longibrachiatum in the Frontline. 2018; unpublished. [Google Scholar]
- Zhou, Y.; Wang, J.; Yang, L.; Guo, L.; He, S.; Zhou, W.; Huang, J. Development of species/genus specific primers for identification of three Trichoderma species and for detection and quantification of Trichoderma genus. Res. Sq. 2021. preprint. [Google Scholar] [CrossRef]
- Jaklitsch, W.M. European species of Hypocrea part II: Species with hyaline ascospores. Fungal Divers. 2011, 48, 1–250. [Google Scholar] [CrossRef] [Green Version]
- O’Donnell, K.; Humber, R.A.; Geiser, D.M.; Kang, S.; Park, B.; Robert, V.A.; Crous, P.W.; Johnston, P.R.; Aoki, T.; Alejandro, P.; et al. Phylogenetic diversity of insecticolous fusaria inferred from multilocus DNA sequence data and their molecular identification via FUSARIUM-ID and Fusarium MLST. Mycologia 2012, 104, 427–445. [Google Scholar] [CrossRef] [Green Version]
- Almeida FB dos, R.; Cerqueira, F.M.; Silva R do, N.; Ulhoa, C.J.; Lima, A.L. Mycoparasitism studies of Trichoderma harzianum strains against Rhizoctonia solani: Evaluation of coiling and hydrolytic enzyme production. Biotechnol. Lett. 2007, 29, 1189–1193. [Google Scholar] [CrossRef] [Green Version]
- Vinale, F.; Sivasithamparam, K.; Ghisalberti, E.L.; Marra, R.; Woo, S.L.; Lorito, M. Trichoderma–plant–pathogen interactions. Soil Biol. Biochem. 2008, 40, 1–10. [Google Scholar] [CrossRef]
- Vinale, F.; Sivasithamparam, K.; Ghisalberti, E.L.; Marra, R.; Barbetti, M.J.; Li, H.; Woo, S.; Lorito, M. A novel role for Trichoderma secondary metabolites in the interactions with plants. Physiol. Mol. Plant Pathol. 2008, 72, 80–86. [Google Scholar] [CrossRef]
- Druzhinina, I.S.; Seidl-Seiboth, V.; Herrera-Estrella, A.; Horwitz, B.A.; Kenerley, C.M.; Monte, E.; Mukherjee, P.K.; Zeilinger, S.; Grigoriev, I.V.; Kubicek, C.P. Trichoderma: The genomics of opportunistic success. Nat. Rev. Microbiol. 2011, 9, 749–759. [Google Scholar] [CrossRef]
- Sood, M.; Kapoor, D.; Kumar, V.; Sheteiwy, M.S.; Ramakrishnan, M.; Landi, M.; Araniti, F.; Sharma, A. Trichoderma: The “secrets” of a multitalented biocontrol agent. Plants 2020, 9, 762. [Google Scholar] [CrossRef]
- Collinge, D.B.; Jensen, D.F.; Rabiey, M.; Sarrocco, S.; Shaw, M.W.; Shaw, R. Biological control of plant diseases—What has been achieved and what is the direction? Plant Pathol. 2022, 71, 1024–1047. [Google Scholar] [CrossRef]
- Cai, F.; Druzhinina, I.S. In honor of John Bissett: Authoritative guidelines on molecular identification of Trichoderma. Fungal Divers. 2021, 107, 1–69. [Google Scholar] [CrossRef]
- Samuels, G.J.; Ismaiel, A.; Bon, M.C.; De Respinis, S.; Petrini, O. Trichoderma asperellum sensu lato consists of two cryptic species. Mycologia 2010, 102, 944–966. [Google Scholar] [CrossRef] [PubMed]
- Samuels, G.J.; Dodd, S.L.; Lu, B.S.; Petrini, O.; Schroers, H.J.; Druzhinina, I.S. The Trichoderma koningii aggregate species. Stud. Mycol. 2006, 56, 67–133. [Google Scholar] [CrossRef] [PubMed] [Green Version]
- Ma, J.; Tsegaye, E.; Li, M.; Wu, B.; Jiang, X. Biodiversity of Trichoderma from grassland and forest ecosystems in Northern Xinjiang, China. 3 Biotech 2020, 10, 362. [Google Scholar] [CrossRef]
- Gajera, H.; Domadiya, R.; Patel, S.; Kapopara, M.; Golakiya, B. Molecular mechanism of Trichoderma as bio-control agents against phytopathogen system–a review. Curr. Res. Microbiol. Biotechnol. 2013, 1, 133–142. [Google Scholar]
- El-Benawy, N.M.; Abdel-Fattah, G.M.; Ghoneem, K.M.; Shabana, Y.M. Antimicrobial activities of Trichoderma atroviride against common bean seed-borne Macrophomina phaseolina and Rhizoctonia solani. Egypt. J. Basic Appl. Sci. 2020, 7, 267–280. [Google Scholar] [CrossRef]
- Chaudhary, S.; Sagar, S.; Lal, M.; Tomar, A.; Kumar, V.; Kumar, M. Biocontrol and growth enhancement potential of Trichoderma spp. against Rhizoctonia solani causing sheath blight disease in rice. J. Environ. Biol. 2020, 41, 1034–1045. [Google Scholar] [CrossRef]
- Da Silva, J.A.T.; de Medeiros, E.V.; da Silva, J.M.; Tenório, D.D.A.; Moreira, K.A.; Nascimento, T.C.E.D.S.; Souza-Motta, C. Trichoderma aureoviride URM 5158 and Trichoderma hamatum URM 6656 are biocontrol agents that act against cassava root rot through different mechanisms. J. Phytopathol. 2016, 164, 1003–1011. [Google Scholar] [CrossRef]
- Mukherjee, P.K.; Mendoza-Mendoza, A.; Zeilinger, S.; Horwitz, B.A. Mycoparasitism as a mechanism of Trichoderma-mediated suppression of plant diseases. Fungal Biol. Rev. 2022, 39, 15–33. [Google Scholar] [CrossRef]
- Hermosa, R.; Cardoza, R.E.; Rubio, M.B.; Gutiérrez, S.; Monte, E. Secondary Metabolism and Antimicrobial Metabolites of Trichoderma. In Biotechnology and Biology of Trichoderma; Elsevier: Amsterdam, The Netherlands, 2014; pp. 125–137. [Google Scholar]
- Rubio, M.B.; Hermosa, R.; Reino, J.L.; Collado, I.G.; Monte, E. Thctf1 transcription factor of Trichoderma harzianum is involved in 6-pentyl-2H-pyran-2-one production and antifungal activity. Fungal Genet. Biol. 2009, 46, 17–27. [Google Scholar] [CrossRef]
- Fadel HH, M.; Mahmoud, M.G.; Asker MM, S.; Lotfy, S.N. Characterization and evaluation of coconut aroma produced by Trichoderma viride EMCC-107 in solid state fermentation on sugarcane bagasse. Electron. J. Biotechnol. 2015, 18, 5–9. [Google Scholar] [CrossRef] [Green Version]
- Mutawila, C.; Vinale, F.; Halleen, F.; Lorito, M.; Mostert, L. Isolation, production and in vitro effects of the major secondary metabolite produced by Trichoderma species used for the control of grapevine trunk diseases. Plant Pathol. 2016, 65, 104–113. [Google Scholar] [CrossRef] [Green Version]
- Hamrouni, R.; Molinet, J.; Miché, L.; Carboué, Q.; Dupuy, N.; Masmoudi, A.; Roussos, S. Production of coconut aroma in solid-state cultivation: Screening and identification of Trichoderma strains for 6-pentyl-alpha-pyrone and conidia production. J. Chem. 2019, 2019, 8562384. [Google Scholar] [CrossRef] [Green Version]
- Pakora, G.A.; Mpika, J.; Kone, D.; Ducamp, M.; Kebe, I.; Nay BBuisson, D. Inhibition of Phytophthora species, agents of cocoa black pod disease, by secondary metabolites of Trichoderma species. Environ. Sci. Pollut. Res. 2018, 25, 29901–29909. [Google Scholar] [CrossRef]
- Sriwati, R.; Chamzurn, T.; Soesanto, L.; Munazhirah, M. Field application of Trichoderma suspension to control cacao pod rot (Phytophthora palmivora). AGRIVITA J. Agric. Sci. 2019, 41, 175–182. [Google Scholar] [CrossRef] [Green Version]
- Sarria, G.; Garcia, A.; Mestizo, Y.; Medina, C.; Varon, F.; Mesa, E.; Hernandez, S. Antagonistic interactions between Trichoderma spp. and Phytophthora palmivora (Butler) from oil palm in Colombia. Eur. J. Plant Pathol. 2021, 161, 751–768. [Google Scholar] [CrossRef]
- Bae, S.J.; Mohanta, T.K.; Chung, J.Y.; Ryu, M.; Park, G.; Shim, S.; Hong, S.-B.; Seo, H.; Bae, D.-W.; Bae, I.; et al. Trichoderma metabolites as biological control agents against Phytophthora pathogens. Biol. Control 2016, 92, 128–138. [Google Scholar] [CrossRef]
- Elsherbiny, E.A.; Amin, B.H.; Aleem, B.; Kingsley, K.L.; Bennett, J.W. Trichoderma volatile organic compounds as a biofumigation tool against late blight pathogen Phytophthora infestans in postharvest potato tubers. J. Agric. Food Chem. 2020, 68, 8163–8171. [Google Scholar] [CrossRef] [PubMed]
- Kubicek, C.P.; Herrera-Estrella, A.; Seidl-Seiboth, V.; Martinez, D.A.; Druzhinina, I.S.; Thon, M.; Zeilinger, S.; Casas-Flores, S.; Horwitz, B.A.; Mukherjee, P.K.; et al. Comparative genome sequence analysis underscores mycoparasitism as the ancestral life style of Trichoderma. Genome Biol. 2011, 12, R40. [Google Scholar] [CrossRef] [PubMed] [Green Version]
- Gruber, S.; Seidl-Seiboth, V. Self versus non-self: Fungal cell wall degradation in Trichoderma. Microbiology 2012, 158, 26–34. [Google Scholar] [CrossRef] [Green Version]
- Wang, S.; Liu, G. Applications of RNA Interference for Enhanced Cellulase Production in Trichoderma. In Biotechnology and Biology of Trichoderma; Elsevier: Amsterdam, The Netherlands, 2014; pp. 201–213. [Google Scholar]
- Seiboth, B.; Ivanova, C.; Seidl-Seiboth, V. Trichoderma reesei: A Fungal Enzyme Producer for Cellulosic Biofuels. In Biofuel Production-Recent Developments and Prospects; InTech: Janeza Trdine, Croatia, 2011; pp. 309–340. [Google Scholar]
- Bartnicki-Garcia, S. Chemistry of hyphal walls of Phytophthora. Microbiology 1966, 42, 57–69. [Google Scholar] [CrossRef] [PubMed] [Green Version]
- Khatri, D.K.; Tiwari, D.N.; Bariya, H.S. Chitinolytic efficacy and secretion of cell wall-degrading enzymes from Trichoderma spp. in response to phytopathological fungi. J. Appl. Biol. Biotechnol. 2017, 5, 1–8. [Google Scholar]
- Ruangwong, O.U.; Pornsuriya, C.; Pitija, K.; Sunpapao, A. Biocontrol mechanisms of Trichoderma koningiopsis PSU3-2 against postharvest anthracnose of chili pepper. J. Fungi. 2021, 7, 276. [Google Scholar] [CrossRef]
- Holtzapple, M.; Cognata, M.; Shu, Y.; Hendrickson, C. Inhibition of Trichoderma reesei cellulase by sugars and solvents. Biotechnol. Bioeng. 1990, 36, 275–287. [Google Scholar] [CrossRef]
- Rabinal, C.; Bhat, S. Identification of differentially expressed genes in Trichoderma koningii IABT1252 during its interaction with Sclerotium rolfsii. Curr. Microbiol. 2020, 77, 396–404. [Google Scholar] [CrossRef]
- Weindling, R. Trichoderma lignorum as a parasite of other soil fungi. Phytopathology 1932, 22, 837–845. [Google Scholar]
- Haran, S.; Schickler, H.; Chet, I. Molecular mechanisms of lytic enzymes involved in the biocontrol activity of Trichoderma harzianum. Microbiology 1996, 142, 2321–2331. [Google Scholar] [CrossRef] [Green Version]
- Kumar, V.; Sharma, D.D.; Babu, A.M.; Datta, R.K. SEM studies on the hyphal interactions between a biocontrol agent Trichoderma harzianum and a mycopathogen Fusarium solani causing root rot disease in mulberry. Indian J. Seric. 1998, 37, 17–20. [Google Scholar]
- Gajera, H.P.; Hirpara, D.G.; Katakpara, Z.A.; Patel, S.V.; Golakiya, B.A. Molecular evolution and phylogenetic analysis of biocontrol genes acquired from SCoT polymorphism of mycoparasitic Trichoderma koningii inhibiting phytopathogen Rhizoctonia solani Kuhn. Infect. Genet. Evol. 2016, 45, 383–392. [Google Scholar] [CrossRef] [PubMed]
- Nawaz, S.; Subhani, M.N.; Chattha, M.B.; Saleem, Y.; Abidi, S.H.; Shahzad, K.; Saeed, S.; Syed, Q.; Irfan, M.; Ambreen, A. Fungal isolates of genus Trichoderma induce wilt resistance to pea caused by Fusarium oxysporum f. sp. pisi through competitive inhibition. Rev. Mex. Ing. Quím. 2021, 20, Bio2475. [Google Scholar] [CrossRef]
- Jiang, H.; Zhang, L.; Zhang, J.; Ojaghian, M.R.; Hyde, K.D. Antagonistic interaction between Trichoderma asperellum and Phytophthora capsici in vitro. J. Zhejiang Univ.-Sci. B 2016, 17, 271–281. [Google Scholar] [CrossRef] [Green Version]
- Rivera-Mendez, W.; Obregon, M.; Moran-Diez, R.M.E.; Hermosa, R.; Monte, E. Trichoderma asperellum biocontrol activity and induction of systemic defenses against Sclerotium cepivorum in onion plants under tropical climate conditions. Biol. Control 2020, 141, 104145. [Google Scholar] [CrossRef]
- Loc, N.H.; Huy, N.D.; Quang, H.T.; Lan, T.T.; Thu Ha, T.T. Characterisation and antifungal activity of extracellular chitinase from a biocontrol fungus, Trichoderma asperellum PQ34. Mycology 2020, 11, 38–48. [Google Scholar] [CrossRef] [Green Version]
- Wonglom, P.; Ito, S.; Sunpapao, A. Volatile organic compounds emitted from endophytic fungus Trichoderma asperellum T1 mediate antifungal activity, defense response and promote plant growth in lettuce (Lactuca sativa). Fungal Ecol. 2020, 43, 100867. [Google Scholar] [CrossRef]
Publisher’s Note: MDPI stays neutral with regard to jurisdictional claims in published maps and institutional affiliations. |
© 2022 by the authors. Licensee MDPI, Basel, Switzerland. This article is an open access article distributed under the terms and conditions of the Creative Commons Attribution (CC BY) license (https://creativecommons.org/licenses/by/4.0/).